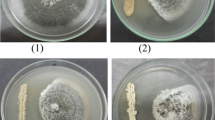

Abstract
Each plant species in nature harbors endophytes, a community of microbes living within host plants without causing any disease symptom. However, the exploitation of endophyte-based phytoprotectants is hampered by the paucity of mechanistic understandings of endophyte-plant interaction. We here reported two endophytic Streptomyces isolates IFB-A02 and IFB-A03 recovered from a stress-tolerant dicotyledonous plant Artemisia annua L. After the determination of their non-pathogenicity at the genomic level and from the toxin (thaxtomin A, TXT) level, the endophytism of both isolates was supported by their successful colonization in planta. Of the two endophytes, IFB-A03 was further studied for the mechanism of endophyte-conferred phytoprotection owing to its plant growth promotion in model eudicot Arabidopsis thaliana. Using the endophyte-Arabidopsis co-cultivation system into which pathogenic Streptomyces scabies was introduced, we demonstrated that IFB-A03 pre-inoculation could activate the salicylic acid (SA)-mediated plant defense responses upon pathogen challenge. Moreover, IFB-A03 was shown to partially rescue the defense deficiency in eds5 (enhanced disease susceptibility 5) Arabidopsis mutants, putatively acting at the upstream of SA accumulation in the defense signaling pathway associated with the systemic acquired resistance (SAR). These data suggest that endophytic Streptomyces sp. IFB-A03 could be a promising candidate for biocontrol agents against S. scabies—a causative pathogen of common scab diseases prevailing in agronomic systems.







Similar content being viewed by others
Abbreviations
- TXT:
-
Thaxtomin A
- SA:
-
Salicylic acid
- eds5 :
-
Enhanced disease susceptibility 5
- SAR:
-
Systemic acquired resistance
References
Arnold AE, Mejía LC, Kyllo D, Rojas EI, Maynard Z, Robbins N, Herre EA (2003) Fungal endophytes limit pathogen damage in a tropical tree. Proc Natl Acad Sci USA 100:15649–15654
Bhakuni RS, Jain DC, Sharma RP, Kuma S (2001) Secondary metabolites of Artemisia annua and their biological activity. Curr Sci 80:35–48
Bindschedler LV, Dewdney J, Blee KA et al (2006) Peroxidase-dependent apoplastic oxidative burst in Arabidopsis required for pathogen resistance. Plant J 47:851–863
Bukhalid RA, Chung SY, Loria R (1998) nec1, a gene conferring a necrogenic phenotype, is conserved in plant-pathogenic Streptomyces spp. and linked to a transposase pseudogene. Mol Plant-Microbe Interact 11:960–967
Cao L, Qiu Z, You J, Tan H, Zhou S (2005) Isolation and characterization of endophytic streptomycete antagonists of Fusarium wilt pathogen from surface-sterilized banana roots. FEMS Microbiol Lett 247:147–152
Castillo UF, Strobel GA, Ford EJ et al (2002) Munumbicins, wide-spectrum antibiotics produced by Streptomyces NRRL 30562, endophytic on Kennedia nigriscans. Microbiolology-SGM 148:2675–2685
Castillo UF, Harper JK, Strobel GA et al (2003) Kakadumycins, novel antibiotics from Streptomyces sp. NRRL 30566, an endophyte of Grevillea pteridifolia. FEMS Microbiol Lett 224:183–190
Conn VM, Walker AR, Franco CMM (2008) Endophytic actinobacteria induce defense pathways in Arabidopsis thaliana. Mol Plant-Microbe Interact 21:208–218
Conrath U, Pieterse CMJ, Mauch-Mani B (2002) Priming in plant–pathogen interactions. Trends Plant Sci 7:210–216
Coombs JT (2002) The isolation and characterization of endophytic actinomycetes from wheat (Triticum aestivum). PhD thesis, Flinders University, Adelaide, Australia
Coombs JT, Franco CMM (2003) Isolation and identification of actinobacteria from surface-sterilized wheat roots. Appl Environ Microbiol 69:5603–5608
Cullen DW, Lees AK (2007) Detection of the nec1 virulence gene and its correlation with pathogenicity in Streptomyces species on potato tubers and in soil using conventional and real-time PCR. J Appl Microbiol 102:1082–1094
Durrant WE, Dong X (2004) Systemic acquired resistance. Annu Rev Phytopathol 42:185–209
Engelberth J, Schmelz EA, Alborn HT, Cardoza YJ, Huang J, Tumlinson JH (2003) Simultaneous quantification of jasmonic acid and salicylic acid in plants by vapor-phase extraction and gas chromatography-chemical ionization-mass spectrometry. Anal Biochem 312:242–250
Ezra D, Castillo UF, Strobel GA et al (2004) Coronamycins, peptide antibiotics produced by a verticillated Streptomyces sp. (MSU-2110) endophytic on Monstera sp. Microbiology-SGM 150:785–793
Feng Y, Shen D, Song W (2006) Rice endophyte Pantoea agglomerans YS19 promotes host plant growth and affects allocations of host photosynthates. J Appl Microbiol 100:938–945
Fulton RW (1986) Practices and precautions in the use of crossprotection for virus disease control. Annu Rev Phytopathol 4:67–81
Guerny KA, Mantle PG (1993) Biosynthesis of 1-N-methylalbonoursin by an endophytic Streptomyces sp. J Nat Prod 56:1194–1199
Gyaneshwar P, James EK, Mathan N, Reddy PM, Reinhold-Hurek B, Ladha JK (2001) Endophytic colonization of rice by a diazotrophic strain of Serratia marcescens. J Bacteriol 83:2634–2645
Hallmann J, Quadt-Hallmann A, Mahaffee WF, Kloepper JW (1997) Bacterial endophytes in agricultural crops. Can J Microbiol 43:895–914
Hasegawa S, Megura A, Shimizu M, Nishimura T, Kunoh H (2006) Endophytic actinomycetes and their interactions with host plants. Actinomycetologica 20:72–81
Healy FG, Bukhalid RA, Loria R (1999) Characterization of an insertion sequence element associated with genetically diverse plant pathogenic Streptomyces spp. J Bacteriol 181:1562–1568
Jackson AO, Talor CB (1996) Plant-microbe interactions: life and death at the interface. Plant Cell 8:1651–1668
Kers JA, Wach MJ, Krasnoff SB, Widom J, Cameron KD, Bukhalid RA, Gibson DM, Crane BR, Loria R (2004) Nitration of a peptide phytotoxin by bacterial nitric oxide synthase. Nature 429:79–82
King RR, Lawrence CH, Clark MC (1991) Correlation of phytotoxin production with pathogenicity of Streptomyces scabies isolates from scab infected potato tubers. Am Potato J 68:675–680
Kuffner M, De Maria S, Puschenreiter M, Fallmann K, Wieshammer G, Gorfer M, Strauss J, Rivelli AR, Sessitsch A (2010) Culturable bacteria from Zn- and Cd-accumulating Salix caprea with differential effects on plant growth and heavy metal availability. J Appl Microbiol 108:1471–1484
Lehr N, Schrey SD, Hampp R, Tarkka MT (2008) Root inoculation with a forest soil streptomycete leads to locally and systemically increased resistance against phytopathogens in Norway spruce. New Phytol 177:965–976
Lerat S, Simao-Beaunoir A, Beaulieu C (2009) Genetic and physiological determinants of Streptomyces scabies pathogenicity. Mol Plant Pathol 10:579–585
Lin L, Tan RX (2011) Cross-kingdom actions of phytohormones: a functional scaffold exploration. Chem Rev 111:2734–2760
Loria R, Bukhalid RA, Creath RA, Leiner RH, Olivier M, Steffens JC (1995) Differential production of thaxtomins by pathogenic Streptomyces species in vitro. Phytopathology 85:537–541
Loria R, Bukhalid RA, Fry BA, King RR (1997) Plant pathogenicity in the genus Streptomyces. Plant Dis 81:836–846
MacKenzie DJ, Tremaine JH (1990) Transgenic Nicotiana debneyii expressing viral coat protein are resistant to potato virus S infection. J Gen Virol 71:2167–2170
Nawrath C, Métraux J-P (1999) Salicylic acid induction-deficient mutants of Arabidopsis express PR-2 and PR-5 and accumulate high levels of camalexin after pathogen inoculation. Plant Cell 11:1393–1404
Pan B, Vessey JK (2001) Response of the endophytic diazotroph Gluconacetobacter diazotrophicus on solid media to changes in atmospheric partial O2 pressure. Appl Environ Microbiol 67:4694–4700
Rodriguez RJ, Henson J, Volkenburgh EV, Hoy M, Wright L, Beckwith F, Kim Y-O, Redman RS (2008) Stress tolerance in plants via habitat-adapted symbiosis. Int Soc Microb Ecol J 2:404–416
Scheible WR, Fry B, Kochevenko A, Schindelasch D, Zimmerli L, Somerville S, Loria R, Somerville CR (2003) An Arabidopsis mutant resistant to thaxtomin A, a cellulose synthesis inhibitor from Streptomyces species. Plant Cell 15:1781–1794
Schrey SD, Tarkka MT (2008) Friends and foes: streptomycetes as modulators of plant disease and symbiosis. Antonie Van Leeuwenhoek 94:11–19
Siciliano SD, Theoret CM, de Freitas JR, Hucl PJ, Germida JJ (1998) Differences in the microbial communities associated with the roots of different cultivars of canola and wheat. Can J Microbiol 44:844–851
Strobel G, Daisy B (2003) Bioprospecting for microbial endophytes and their natural products. Microbiol Mol Biol Rev 67:491–502
Tamaoki M, Freeman JL, Pilon-Smits EAH (2008) Cooperative ethylene and jasmonic acid signaling regulates selenite resistance in Arabidopsis. Plant Physiol 146:1219–1230
Tamura K, Dudley J, Nei M, Kumar S (2007) MEGA4: molecular evolutionary genetics analysis (MEGA) software version 4.0. Mol Biol Evol 24:1596–1599
Tan RX, Zou WX (2001) Endophytes: a rich source of functional metabolites. Nat Prod Rep 18:448–459
Tan RX, Zheng WF, Tang HQ (1998) Biologically active substances from the genus Artemisia. Planta Med 64:295–302
Tanaka A, Christensen MJ, Takemoto D, Park P, Scotta B (2006) Reactive oxygen species play a role in regulating a fungus-perennial ryegrass mutualistic interaction. Plant Cell 18:1052–1066
Thomas P, Soly TA (2009) Endophytic bacteria associated with growing shoot tips of banana (Musa sp.) cv. grand naine and the affinity of endophytes to the host. Microb Ecol 58:952–964
Tokala RK, Strap JL, Jung CM, Crawford DL, Salove MH, Deobald LA, Bailey JF, Morra MJ (2002) Novel plant-microbe rhizosphere interaction involving Streptomyces lydicus WYEC108 and the pea plant (Pisum sativum). Appl Environ Microbiol 68:2161–2171
van Loon LC, Rep M, Pieterse CMJ (2006) Significance of inducible defense-related proteins in infected plants. Annu Rev Phytopathol 44:135–162
Wang Y, Zhang Z, Ruan J (1996) Phylogenetic analysis reveals new relationships among members of the genera Microtetraspora and Microbispora. Int J Syst Bacteriol 46:658–663
Wojtaszek P (1997) The oxidative burst: a plant’s early response against infection. Biochem J 322:681–692
Zhao G-Z, Li J, Qin S, Huang H-Y, Zhu W-Y, Xu L-H, Li W-J (2010) Streptomyces artemisiae sp. nov., isolated from surface-sterilized tissue of Artemisia annua L. Int J Syst Evol Microbiol 60:27–32
Acknowledgments
We thank Profs S. Lu (Nanjing Univ.) and D. T. Ren (China Agric. Univ.) for providing seeds of wild-type Col-0 and eds5 mutant, NahG transgenic Arabidopsis thaliana, respectively, and Prof. Z. Hong (Nanjing Univ.) for helpful suggestions on the manuscript. We are also grateful to the two anonymous referees for their comments and advice for the improvement of manuscript. This work was co-financed by grants from NSFC (30821006 & 90813036) and MOST (2009ZX09501-013).
Conflict of interest
The authors declare that they have no conflict of interest.
Author information
Authors and Affiliations
Corresponding author
Additional information
Data deposition: The 16S rRNA gene sequences for the two endophytic isolates IFB-A02 and IFB-A03 mentioned here have been deposited in the GenBank database (accession no. HQ317204-317205).
Electronic supplementary material
Below is the link to the electronic supplementary material.
Rights and permissions
About this article
Cite this article
Lin, L., Ge, H.M., Yan, T. et al. Thaxtomin A-deficient endophytic Streptomyces sp. enhances plant disease resistance to pathogenic Streptomyces scabies . Planta 236, 1849–1861 (2012). https://doi.org/10.1007/s00425-012-1741-8
Received:
Accepted:
Published:
Issue Date:
DOI: https://doi.org/10.1007/s00425-012-1741-8